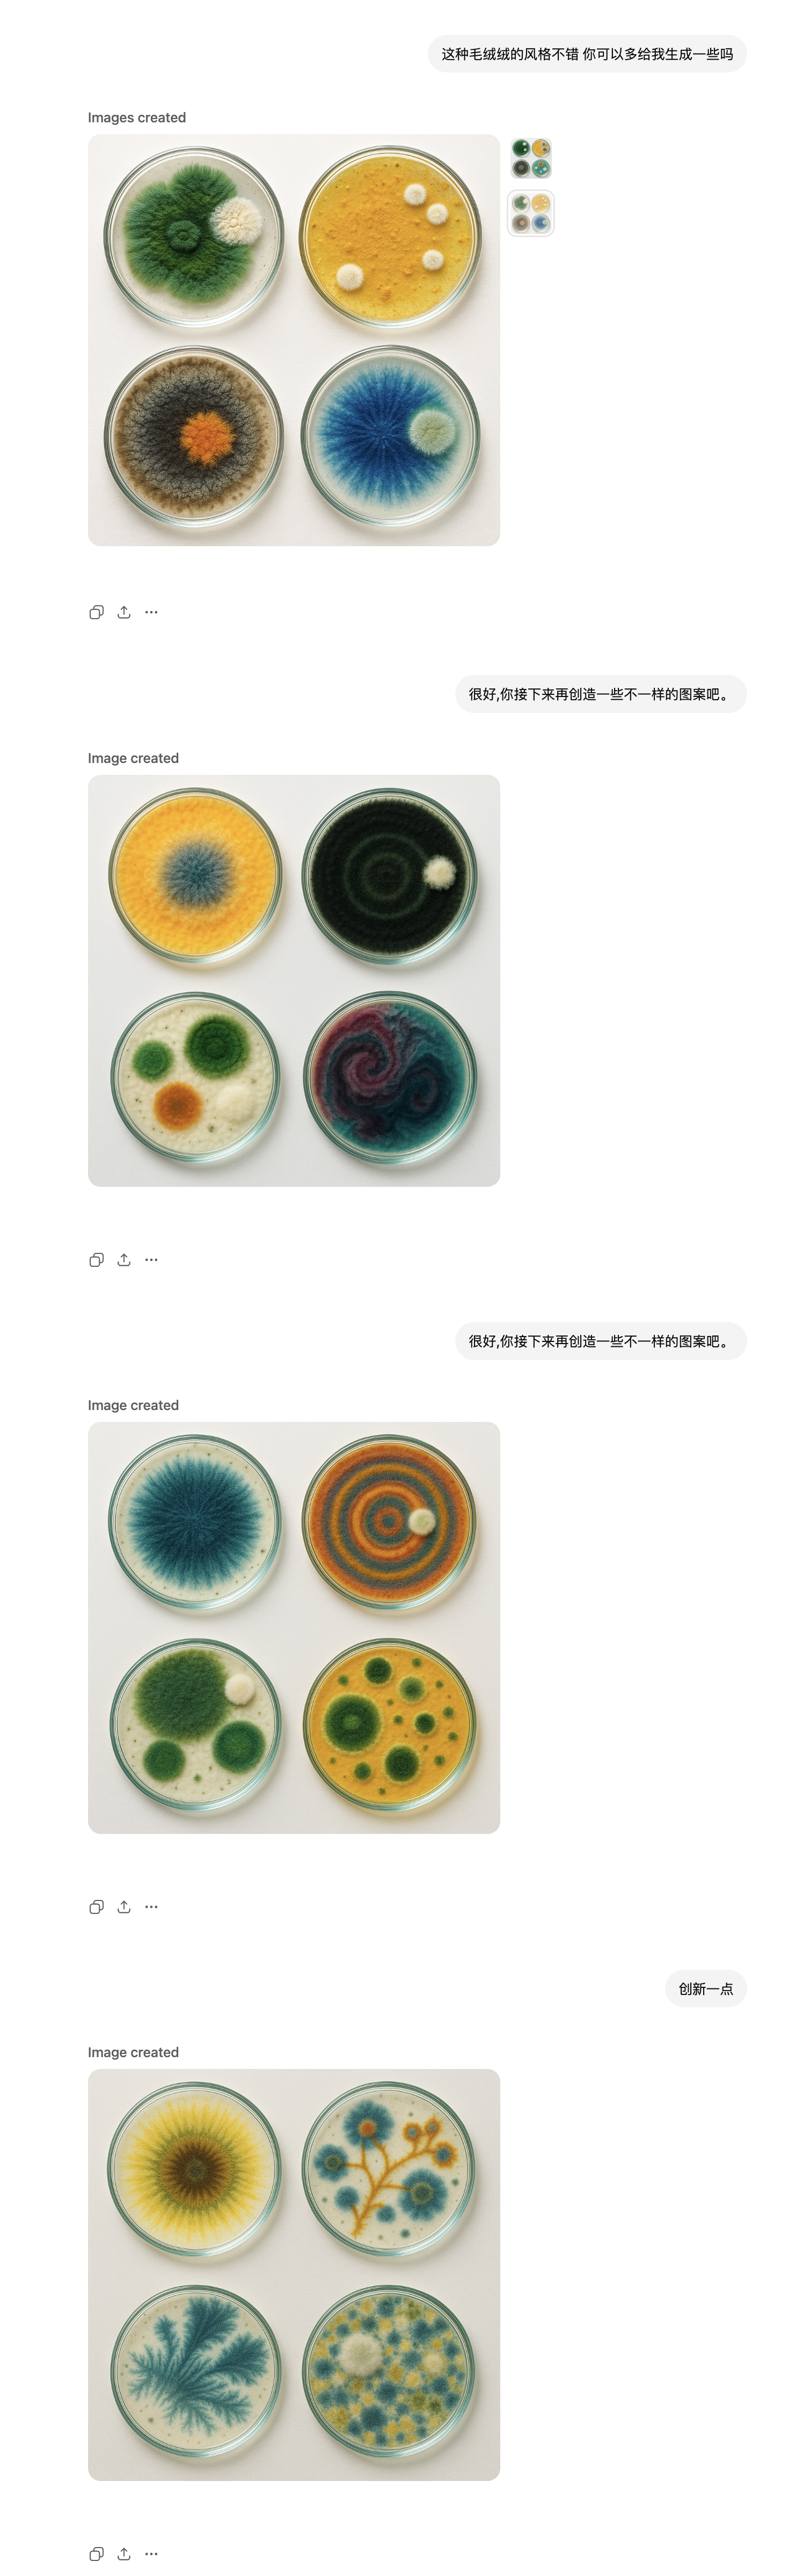

即刻App年轻人的同好社区
下载
1. 在可计算性上,人脑 ≈ 神经网络 ≈ 图灵机
2. 图灵机无法解决停机问题
3. 人脑无法解决停机问题
4. 人脑没有通用的方式来判定一个问题是否能在有限的时间内找到解答
5. 人脑没有通用的方式来预估解决问题所需的时间
6. 有些问题需要很长时间才能解答,甚至无法解答,而你一开始却无法知道
2. 图灵机无法解决停机问题
3. 人脑无法解决停机问题
4. 人脑没有通用的方式来判定一个问题是否能在有限的时间内找到解答
5. 人脑没有通用的方式来预估解决问题所需的时间
6. 有些问题需要很长时间才能解答,甚至无法解答,而你一开始却无法知道
8 114
分享一下,我是如何使用 AI ,为 Molday. 设计一套奖章的
总体上分成 4 个步骤:
1. 让 AI 探索不同的视觉风格(图1、2、3)
2. 生成多张风格一致的奖章(图3)
3. 让 AI 写脚本把奖章处理成尺寸一致的(图4、5)
4. 把图片添加到 App 里面(图6)
1️⃣步骤1
在开始前,我只知道我想要是类似于培养皿的图案,以符合 App 发霉的设定,但是我并不知道什么样的风格合适。
于是,我就简单描述了一下自己需求,让它开始生成(图1),在过程中,我会让它尝试不同的风格,尝试了很多次都不满意。
试了很多次之后,产生了一个毛绒绒风格的图案,我觉得还不错,看着也很像发霉的样子,于是就让它用这个风格生成更多的图案(图2)
不过,这个风格和 Molday. 的不是很搭,所以还是抛弃掉了。
但是我觉得中间产生的图案还挺好看的,所以就让它根据这些图案,生成风格不一致的图片(图3),最后采用了扁平化的风格。
2️⃣步骤2
确定好风格后,接下来就是,如何保持风格一致,生成多个图案不一样的图片。
我会创建很多个对话,在对话的开头把之前生成的图片,作为样例发给AI,让它继续生成图案不同的图片。
不同对话生成的图片质量不一样,有的好,有的差。这个时候我会用到 ChatGPT 的 Branch 功能,把效果好的对话,进行分叉创建很多新的对话,在新的对话里面继续生成。由于新对话有相同的上下文,所以生成的质量也会好一点。
不断的重复生成,就有几十张图片了。
这个基本就是一个苦力活了,偶尔需要给 AI 一些方向。
3️⃣步骤3
生成的图片有一些问题,无法直接放到 App 里面。
我要的图案是一个圆形,但是图片本身又只能是矩形,只不过有着透明的背景。
问题在于,不同的图片里的圆形,比例大小是不一样的。所以,即便我限制了不同图片外面矩形的尺寸保持一致,里面的图形大小却会不一样。
此外,有的圆形都不是正圆,甚至长了疙瘩。
(图4,左侧2张是处理前的,右侧2张是处理后的)
所以,我就需要对图片进行处理,一是让圆形和外面的矩形相切,这样能保证图片尺寸一致时,里面的圆形尺寸也会是一致的,以及把图形处理成正圆。
如果没有 AI,这件事处理起来不知道会有多复杂。
我把图片放到了一个文件夹里,然后跟 codex 说明了需求,让它写个脚本处理一下。
(原始对话找不到了,图4对话里的消息是为了演示新发的)
codex 先去查看了一下图片,然后就开始写代码了,写完代码运行后,它会去检查一下处理得怎么样。虽然中间几次没有处理的效果没有很好,但最后还是完成任务了。
4️⃣步骤4
最后,就是把图片拖到 App 的代码项目里面,让 AI 把它展示出来了。(图6)
总体上分成 4 个步骤:
1. 让 AI 探索不同的视觉风格(图1、2、3)
2. 生成多张风格一致的奖章(图3)
3. 让 AI 写脚本把奖章处理成尺寸一致的(图4、5)
4. 把图片添加到 App 里面(图6)
1️⃣步骤1
在开始前,我只知道我想要是类似于培养皿的图案,以符合 App 发霉的设定,但是我并不知道什么样的风格合适。
于是,我就简单描述了一下自己需求,让它开始生成(图1),在过程中,我会让它尝试不同的风格,尝试了很多次都不满意。
试了很多次之后,产生了一个毛绒绒风格的图案,我觉得还不错,看着也很像发霉的样子,于是就让它用这个风格生成更多的图案(图2)
不过,这个风格和 Molday. 的不是很搭,所以还是抛弃掉了。
但是我觉得中间产生的图案还挺好看的,所以就让它根据这些图案,生成风格不一致的图片(图3),最后采用了扁平化的风格。
2️⃣步骤2
确定好风格后,接下来就是,如何保持风格一致,生成多个图案不一样的图片。
我会创建很多个对话,在对话的开头把之前生成的图片,作为样例发给AI,让它继续生成图案不同的图片。
不同对话生成的图片质量不一样,有的好,有的差。这个时候我会用到 ChatGPT 的 Branch 功能,把效果好的对话,进行分叉创建很多新的对话,在新的对话里面继续生成。由于新对话有相同的上下文,所以生成的质量也会好一点。
不断的重复生成,就有几十张图片了。
这个基本就是一个苦力活了,偶尔需要给 AI 一些方向。
3️⃣步骤3
生成的图片有一些问题,无法直接放到 App 里面。
我要的图案是一个圆形,但是图片本身又只能是矩形,只不过有着透明的背景。
问题在于,不同的图片里的圆形,比例大小是不一样的。所以,即便我限制了不同图片外面矩形的尺寸保持一致,里面的图形大小却会不一样。
此外,有的圆形都不是正圆,甚至长了疙瘩。
(图4,左侧2张是处理前的,右侧2张是处理后的)
所以,我就需要对图片进行处理,一是让圆形和外面的矩形相切,这样能保证图片尺寸一致时,里面的圆形尺寸也会是一致的,以及把图形处理成正圆。
如果没有 AI,这件事处理起来不知道会有多复杂。
我把图片放到了一个文件夹里,然后跟 codex 说明了需求,让它写个脚本处理一下。
(原始对话找不到了,图4对话里的消息是为了演示新发的)
codex 先去查看了一下图片,然后就开始写代码了,写完代码运行后,它会去检查一下处理得怎么样。虽然中间几次没有处理的效果没有很好,但最后还是完成任务了。
4️⃣步骤4
最后,就是把图片拖到 App 的代码项目里面,让 AI 把它展示出来了。(图6)

56 18
Molday. 将 屏幕使用时间 具象化成 培养皿上的霉点,让你可以观察自己发霉的状态。
和大部分专注类 App 不同,我们不会一上来就问你一大堆问题,然后告诉你在浪费生命。
相反,我们提供的是一个让你可以观察自己的窗口。具体想要怎么做,完全由你自己来决定。
你可以就这么放着不管,也可以进行干预,甚至还能叫上你的好友来帮助你。
在「自然」模式下,你可以只观察,平时怎么样就还是怎么样。
当你观察到,最近几天发霉有点严重了,你可以打开「真空」模式,设定应用限额,时间到了,应用就会被锁定。
和苹果自带的应用限额一样,在「真空」模式下,我们不会强制锁定应用,毕竟可能真的有急事呢。如果你依然想要继续使用,你可以选择临时解除锁定几分钟。
如果你想要更加强制的干预,你可以进入「守护」模式,让你的好友来监督你。
这时,当应用锁定后,如果想要继续发霉,得发送iMessage 让你的好友同意。
如果你觉得培养皿的图案不够丰富,在你持续记录的时候,你就可以解锁一个个好看的印记。
和大部分专注类 App 不同,我们不会一上来就问你一大堆问题,然后告诉你在浪费生命。
相反,我们提供的是一个让你可以观察自己的窗口。具体想要怎么做,完全由你自己来决定。
你可以就这么放着不管,也可以进行干预,甚至还能叫上你的好友来帮助你。
在「自然」模式下,你可以只观察,平时怎么样就还是怎么样。
当你观察到,最近几天发霉有点严重了,你可以打开「真空」模式,设定应用限额,时间到了,应用就会被锁定。
和苹果自带的应用限额一样,在「真空」模式下,我们不会强制锁定应用,毕竟可能真的有急事呢。如果你依然想要继续使用,你可以选择临时解除锁定几分钟。
如果你想要更加强制的干预,你可以进入「守护」模式,让你的好友来监督你。
这时,当应用锁定后,如果想要继续发霉,得发送iMessage 让你的好友同意。
如果你觉得培养皿的图案不够丰富,在你持续记录的时候,你就可以解锁一个个好看的印记。









76 611
你们养过最奇怪的宠物是什么?
说起来你可能不信,我最近在养霉菌。
而且它改变了我的生活。
每一天,我都会准备一个空的培养皿。
不一会,我就会看到上面出现了第 1 个霉点。
这个霉点的颜色很重要,因为我知道今天接下来的霉点也都会是同一个色系的。
前天是紫的,昨天是蓝的,今天是绿的。
只有一个霉点其实有点无聊。
不过,接下来就会出现第 2 个霉点、第 3 个霉点…
培养皿很快就会变得热闹起来
(希望没有一个霉点是社恐
在一天的不同时刻,我总会去悄悄的看看培养皿,看看长成什么样子了。
下午时分,已经有不少的霉点了,还怪好看的,它们是波点艺术大师吧。
到了晚上,一个培养皿长成什么样子,霉点的多少,已经基本定型了,不过有些晚上居然还会迅速长出很多霉点。
培养皿上霉点的数量,到底和什么有关系呢?
和空气湿度有关吗?不是。
和颜色有关吗?也不是。
我发现有几个晚上,手机电量比较少,那几天霉点的数量明显比往日更多。
霉菌以电为食?
我发现和电量确实有相关性,但并不准确。
难道是手机的屏幕使用时间?
我对比了最近一周的数据,居然发现两者居然是线性相关的。
如果使用手机越久,培养皿上的霉点数量就会越多。
可是这怎么可能呢?
霉菌怎么会知道我用了多久手机?
排除一切不可能,剩下最后一个可能性,不论多么不可思议,它都会是真相。
真相是,这个培养皿其实是在一个 App 里面的,而这个 App 会把系统的屏幕使用时间告诉霉菌。
我玩手机的时候,到底是我在发霉,还是培养皿在发霉?
这就是我养过最奇怪的宠物了。
如果你也想拥有它,可以在 App Store,搜索 Molday. ,你就可以开始养霉菌了。
(设计:@Klein.W59 ;开发:@zhijie )
(另外,点开看设计者的心路历程 👇)
说起来你可能不信,我最近在养霉菌。
而且它改变了我的生活。
每一天,我都会准备一个空的培养皿。
不一会,我就会看到上面出现了第 1 个霉点。
这个霉点的颜色很重要,因为我知道今天接下来的霉点也都会是同一个色系的。
前天是紫的,昨天是蓝的,今天是绿的。
只有一个霉点其实有点无聊。
不过,接下来就会出现第 2 个霉点、第 3 个霉点…
培养皿很快就会变得热闹起来
(希望没有一个霉点是社恐
在一天的不同时刻,我总会去悄悄的看看培养皿,看看长成什么样子了。
下午时分,已经有不少的霉点了,还怪好看的,它们是波点艺术大师吧。
到了晚上,一个培养皿长成什么样子,霉点的多少,已经基本定型了,不过有些晚上居然还会迅速长出很多霉点。
培养皿上霉点的数量,到底和什么有关系呢?
和空气湿度有关吗?不是。
和颜色有关吗?也不是。
我发现有几个晚上,手机电量比较少,那几天霉点的数量明显比往日更多。
霉菌以电为食?
我发现和电量确实有相关性,但并不准确。
难道是手机的屏幕使用时间?
我对比了最近一周的数据,居然发现两者居然是线性相关的。
如果使用手机越久,培养皿上的霉点数量就会越多。
可是这怎么可能呢?
霉菌怎么会知道我用了多久手机?
排除一切不可能,剩下最后一个可能性,不论多么不可思议,它都会是真相。
真相是,这个培养皿其实是在一个 App 里面的,而这个 App 会把系统的屏幕使用时间告诉霉菌。
我玩手机的时候,到底是我在发霉,还是培养皿在发霉?
这就是我养过最奇怪的宠物了。
如果你也想拥有它,可以在 App Store,搜索 Molday. ,你就可以开始养霉菌了。
(设计:@Klein.W59 ;开发:@zhijie )
(另外,点开看设计者的心路历程 👇)

Klein.W59: 去年我给自己放了一年的假 主打休息+顺带做任何感兴趣的事情 也是挺奇怪,没有了组织的鞭策和责任的驱动 我完全丧失专注力 很难说到底是因为方向太多以至于无法聚焦 还是ADHD (不会吧 我扎扎实实的看不进任何东西 更让人不安的,是心里那些矛盾的声音 “我值得一个心安理得的长假” “活在2025,哪有不FOMO” 唯一确定的是,我可以要求自己动起来 但如果我什么都不做,也希望自己是被全然接受的 尤其在我度过了很多时光,但没收获什么的地方,需要这种“接受” ——我的屏幕时间 于是就有了「 Molday. 某天 」这个App: 这是一个可以安心待着的地方 不被追赶,不被评判 打开App,一只培养皿 使用了屏幕,就开始发霉 时间越久,霉斑就蔓延得越多 没有折线图,没有评分 没有“比昨天减少15%” 只有一只培养皿,如实记录着当天的状态 矛盾人士也设想了这三个模式: · 自然:既然霉斑自由蔓延,那就蔓延吧。这是你原本的生态,我们只观察,不修剪 · 真空:偶尔我攒够了力气,想清理一下自己,就划一道温柔的边界 · 守护:如果连清理的力气都没了,就把“钥匙”交给信任的人,让另一个人拉我上岸 断断续续地规划修改、暂停再修改…… 中间停过好几次,有时候是忙别的事情,有时候是因为又进入了使不上劲的状态 等到这个App真正上架时,现在的状态已经没那么“发霉”了 时间真是个奇怪的东西 我为自己造了一把伞,等伞造好,雨已经停了 但我想,雨可能还会再来 或者,它正在别人那里 所以还是把 Molday. 发出来了 如果你现在正在某个潮湿的角落里 这里没有审视,也没有KPI 你可以带着 Molday. 继续发霉 或者,慢慢放晴
14 62
最近陆续看到看多关于「互动内容」的讨论和产品,我对此挺感兴趣的,不过目前没有看到一个可以「刷」得起来的产品。
## 这看似是一个很有意思的方向:
1. 软件的分发是否有可能发生改变?我们已经用推荐引擎来分发内容了,是否可以同样的方式来分发网站。
2. 把长媒介变成短媒介会怎么样?从博客变成微博,从长视频变成短视频,消费和创作变简单了,如果把「长网站」变成「短网站」呢?
3. 可编程的社交媒体。现有的社交媒体,用户与用户之间的互动形式都是平台规定的,目前互动的形式相对单一,如果可以由用户自定义可编程呢?
如果世界上所有人都可以编程,并且可以在1秒内写下1000行代码,会怎么样?
4. Alan Kay 说:软件是一种元媒介。软件可以包含其它媒介,其它媒介能干能表达的事情,软件都能做。麦克卢汉说:媒介即信息。短视频是一种热媒介,而软件是一种冷媒介。
还有很多视角可以看待这件事情,在此就不展开了。
## 但需要回答:
1. 媒介的竞争。一个人为什么不去刷短视频/小红书,而来刷互动内容呢?甚至有些互动内容做成视频反而更好。
2.交互究竟有什么用?
交互是有害的。Bret Victor 在文章 Magic Ink 中将软件分为:操作型软件,信息型软件。信息型软件应减少交互,而应该用可视化的方式呈现,眼睛比手快。
交互当然有价值,但引入交互增加的认知成本,需要加倍的回报。多邻国是一个好实践。
## 一些尝试和实践
在这波 AI 以前其实就有很多把「软件作为内容」的尝试了。
1. 点击按钮随机进入一个网页:
clicktheredbutton.com
2. 可探索解释,这是bret victotr提出的一个概念。这些例子将交互作为内容的一部分,不过他们不是短内容,而是长内容:
explorabl.es
neal.fun
ncase.me
pudding.cool
3. 每张卡片是一个游戏
[Make and post games, all on your phone.](castle.xyz)
AI 出现后,又有了一堆产品:
4. 短内容 APP:Gizmo(目前看到做得最好的,但是很难刷得起来),Aippy
5. 灵光:在AI的回复里面增加了一些可视化的部分,也可以有一些交互,但是效果比较一般
6. vibary.art,这是我前不久做的一个项目,用网页来呈现书籍的内容,这个也是长内容
如果你去尝试上面的产品,你会发现部分的内容还是不错的,但就是很难刷起来。
现在的这些形态,会有一些用户会去玩一玩的,但是很难进一步扩大用户群,除非它们的产品形态有进一步的创新。
## 这看似是一个很有意思的方向:
1. 软件的分发是否有可能发生改变?我们已经用推荐引擎来分发内容了,是否可以同样的方式来分发网站。
2. 把长媒介变成短媒介会怎么样?从博客变成微博,从长视频变成短视频,消费和创作变简单了,如果把「长网站」变成「短网站」呢?
3. 可编程的社交媒体。现有的社交媒体,用户与用户之间的互动形式都是平台规定的,目前互动的形式相对单一,如果可以由用户自定义可编程呢?
如果世界上所有人都可以编程,并且可以在1秒内写下1000行代码,会怎么样?
4. Alan Kay 说:软件是一种元媒介。软件可以包含其它媒介,其它媒介能干能表达的事情,软件都能做。麦克卢汉说:媒介即信息。短视频是一种热媒介,而软件是一种冷媒介。
还有很多视角可以看待这件事情,在此就不展开了。
## 但需要回答:
1. 媒介的竞争。一个人为什么不去刷短视频/小红书,而来刷互动内容呢?甚至有些互动内容做成视频反而更好。
2.交互究竟有什么用?
交互是有害的。Bret Victor 在文章 Magic Ink 中将软件分为:操作型软件,信息型软件。信息型软件应减少交互,而应该用可视化的方式呈现,眼睛比手快。
交互当然有价值,但引入交互增加的认知成本,需要加倍的回报。多邻国是一个好实践。
## 一些尝试和实践
在这波 AI 以前其实就有很多把「软件作为内容」的尝试了。
1. 点击按钮随机进入一个网页:
clicktheredbutton.com
2. 可探索解释,这是bret victotr提出的一个概念。这些例子将交互作为内容的一部分,不过他们不是短内容,而是长内容:
explorabl.es
neal.fun
ncase.me
pudding.cool
3. 每张卡片是一个游戏
[Make and post games, all on your phone.](castle.xyz)
AI 出现后,又有了一堆产品:
4. 短内容 APP:Gizmo(目前看到做得最好的,但是很难刷得起来),Aippy
5. 灵光:在AI的回复里面增加了一些可视化的部分,也可以有一些交互,但是效果比较一般
6. vibary.art,这是我前不久做的一个项目,用网页来呈现书籍的内容,这个也是长内容
如果你去尝试上面的产品,你会发现部分的内容还是不错的,但就是很难刷起来。
现在的这些形态,会有一些用户会去玩一玩的,但是很难进一步扩大用户群,除非它们的产品形态有进一步的创新。
37 1423
如果你能对每条IM消息进行编程。
事情的起因是,今天打算发送一张图片给微信好友,但是担心对方在上班,万一当众把图片打开就社死了。
于是想到,要是IM软件可以让你在发送图片的时候,自定义图片的显示效果就好了,例如对方看到图片是有一层模糊效果的,需要手指滑动才能看到原图片。
这个时候灵光一现,何必只是图片呢,只是这个效果呢?如果对于每一条消息,用户都能选择如何显示以及会有什么效果呢?
用户在发送消息时,可以由AI推荐效果,也能由用户自己输入。接着 AI 就可以根据文字描述写好代码,最好代码就能随消息一起发送出去,并显示在屏幕上。
有了这个想法后,就在 ai studio 上让 gemini 写了一个 demo,就是视频的这个样子了。
事情的起因是,今天打算发送一张图片给微信好友,但是担心对方在上班,万一当众把图片打开就社死了。
于是想到,要是IM软件可以让你在发送图片的时候,自定义图片的显示效果就好了,例如对方看到图片是有一层模糊效果的,需要手指滑动才能看到原图片。
这个时候灵光一现,何必只是图片呢,只是这个效果呢?如果对于每一条消息,用户都能选择如何显示以及会有什么效果呢?
用户在发送消息时,可以由AI推荐效果,也能由用户自己输入。接着 AI 就可以根据文字描述写好代码,最好代码就能随消息一起发送出去,并显示在屏幕上。
有了这个想法后,就在 ai studio 上让 gemini 写了一个 demo,就是视频的这个样子了。
01:00
64 2016